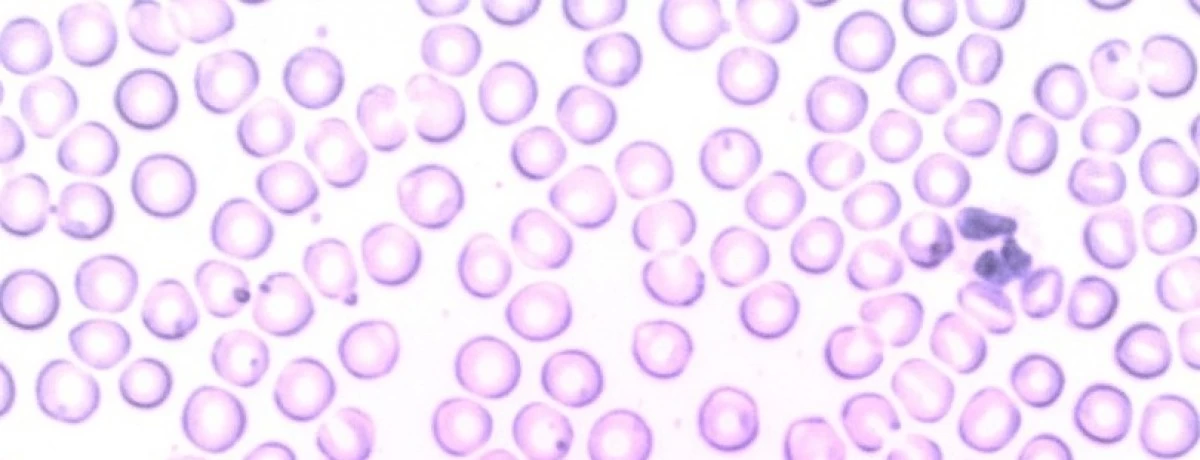

- Come si definisce l’anergia?
- Come funziona il sistema immunitario?
- Quali sono i componenti del sistema immunitario?
- Quali sono le cause di una condizione anergica?
- Che differenza c’è tra anergia e astenia?
- In che modo intervenire per risolvere l’anergia?
- Come rinforzare il sistema immunitario?
Come si definisce l’anergia?
↑ topL’anergia è il termine che viene dato alla mancanza di risposta immunitaria, rispetto ad una specifica sostanza estranea, ad un agente patogeno o ad agenti esterni. In altre parole, le linee di difesa dell’organismo vengono meno.
Le sostanze esterne verso cui si produce una risposta immunitaria prendono il nome di antigeni. Questi sono sostanze che, una volta introdotte nei tessuti o nel sangue, provocano la formazione di anticorpi.
Prenota una visita specialistica
Come funziona il sistema immunitario?
↑ topIl meccanismo di difesa dell’organismo si sviluppa su tre livelli. Si parla di:
- immunità innata o aspecifica, quando si ha una attivazione del sistema immunitario si attiva contro un qualsiasi agente estraneo in modo naturale, senza che sia stato necessario alcun contatto precedente con il patogeno
- immunità acquisita o specifica, quando si sviluppa per gradi, instaurandosi in seguito ad un primo contatto. Questo tipo di immunità può essere naturale oppure artificiale, come nel caso delle vaccinazioni
- immunità meccanica o chimica, quando l’organismo pone in essere barriere quali sudore, pH acido dello stomaco, sebo, per scongiurare l’ingresso di agenti esterni.
Quali sono i componenti del sistema immunitario?
↑ topLe cellule del sistema immunitario sono prodotte all’interno del midollo osseo. Le cellule maggiormente importanti, che sono prodotte dal sistema immunitario, si trovano nei vasi sanguigni e sono:
- i fagociti, particolari globuli bianchi appartenenti alla difesa aspecifica, in grado di fagocitare gli agenti esterni
- i linfociti, i globuli bianchi capaci di modificare gli anticorpi contro specifici agenti patogeni.
I linfociti possono essere poi di due tipi:
- linfociti B, prodotti nel midollo osseo e con l’obiettivo di produrre gli anticorpi. Gli anticorpi sono proteine in grado di intercettare uno specifico antigene, così da legarsi ad esso e infine neutralizzarlo
- linfociti T, prodotti nel timo, una ghiandola linfatica a regolazione e coordinamento del sistema immunitario nella sua totalità.
Accanto ai globuli bianchi e agli anticorpi, possono essere ricordati anche i linfonodi e i vasi linfatici, ricompresi nel sistema linfatico, predisposto alla circolazione dei globuli bianchi. È nei linfonodi che le cellule del sistema immunitario si riproducono a contrasto di un dato agente patogeno. I linfonodi ingrossati possono essere sintomo di infezioni di tipo virale o batterico.
Quali sono le cause di una condizione anergica?
↑ topL’anergia non può essere considerata di per sé una patologia, quanto il sintomo di una condizione sottostante. Sotto questo punto di vista, una condizione di anergia può essere dovuta all’assunzione di alcuni farmaci, come ad esempio gli antistaminici.
L’anergia può essere inoltre secondaria rispetto a diverse patologie a carico del sistema immunitario e dei linfociti. Patologie quali:
- linfoma, un tipo di tumore che aggredisce il sistema linfatico
- AIDS, la sindrome da immunodeficienza acquisita causata dal virus dell’HIV
- malattie autoimmuni, patologie che si specificano per una disfunzione del sistema immunitario.
Che differenza c’è tra anergia e astenia?
↑ topL’astenia può essere definita come un senso diffuso di debolezza, stanchezza o, ancora, mancanza di energia, che determina una diminuita capacità sia fisica che mentale, un affaticamento facilmente raggiungibile e una scarsa resistenza allo sforzo.
Quando si parla di astenia, inoltre, ci si riferisce ad un sintomo aspecifico riconducibile ad un numero piuttosto nutrito di condizioni patologiche quali infezioni croniche, come nelle epatiti virali, nelle patologie a carico del sistema endocrino come l’ipotiroidismo o il diabete. Oppure nei tumori o nelle intossicazioni.
In che modo intervenire per risolvere l’anergia?
↑ topUna condizione di anergia può essere gestita a partire dal trattamento, ed eventualmente la risoluzione, della patologia sottostante.
In seconda battuta, possono essere svolte diverse scelte, relative allo stile di vita, per rinforzare il sistema immunitario.
Prenota una visita specialistica
Come rinforzare il sistema immunitario?
↑ topIl sistema immunitario può essere rinforzato attuando diverse sane abitudini:
- praticare in modo adatto alle proprie possibilità, e con regolarità, della attività fisica
- nutrirsi in modo completo e consapevole, introducendo alimenti che aiutano il sistema immunitario, senza dimenticare l’assunzione di vitamine
- prendendosi cura del microbiota intestinale, l’insieme dei microrganismi presenti all’interno dell’intestino, che tra le diverse funzioni ha quella di regolare la risposta immunitaria.
La scelta di una alimentazione che sia di vantaggio per il sistema immunitario deve essere fatta anche a vantaggio dei soggetti più piccoli.